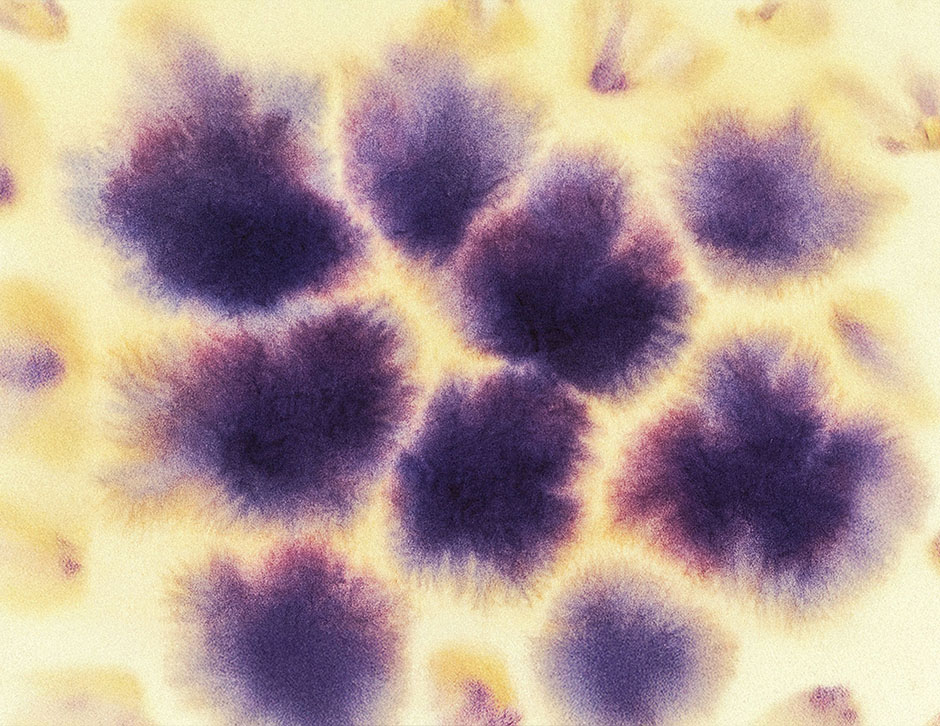
Microdosing GLP-1 and LDN: A Powerful Duo for Inflammation

AgelessRx Blog
- Acarbose
- Aging Skin
- All Posts
- Alzheimer's
- Atorvastatin
- B12
- Bioage
- Blood Pressure
- Cancer
- CGM
- Cognitive Health
- Company News
- Core Longevity Panel
- Diabetes
- DMAE
- Dog Aging
- Energy & Fatigue
- Featured
- GLP-1
- Glutathione
- Hair Loss
- Health Monitoring
- Heart Disease
- In the News
- LDN
- Longevity Science
- Longevity Spotlight
- Longevity Tips
- Metformin
- Methylene Blue
- Microdosing GLP-1
- Muscle
- NAD+
- New
- newsletter
- Rapamycin
- Sermorelin
- SGLT2
- Skin
- Sleep
- Smoking
- Stress
- Supplements
- Tadalafil
- Testing
- Trazodone
- Tretinoin
- Weight
- Women's Health
- XPRIZE
-

Six Risk Factors That Impact Your Longevity
Chronic health conditions can seem like an inevitable part of aging. The good news? Many chronic diseases are completely preventable.
-
Microdosing GLP-1 and LDN: A Powerful Duo for Inflammation
Discover how Microdosing GLP-1 alongside LDN may target chronic inflammation, supports immune balance, and offer benefits beyond weight loss. Read More
-

Feeling Lost in the GLP-1 Maze? Here’s Your Simple Guide
A simple GLP-1 guide that explains eligibility, dosing, microdosing, and how these medications support metabolic health and longevity. Read More
-

What Chronic Fatigue Teaches Us About Aging, Immunity, and Cellular Repair
Here’s what we’ll cover in this blog post: Some people get sick and recover. Others never quite make it back. For roughly three million Americans living with Chronic Fatigue Syndrome … Continue reading “What Chronic Fatigue Teaches Us About Aging, Immunity, and Cellular Repair” Read More
-

#TheLongevityHapps: Insights from Our Resident Geroscientist
Take a look at AgelessRx geroscientist Girish’s newest longevity insights. You don’t want to miss these! Read More
-

A Guide to GLP-1s
A guide to GLP-1s for weight loss and longevity. Compare Wegovy, Ozempic, Mounjaro, Tirzepatide, and Zepbound with micro- vs. macro-dosing. Read More
-

Djokovic’s Longevity Strategies: Turning Age Into Competitive Edge
Learn how Djokovic’s longevity strategies mirror science-backed AgelessRx strategies, proving performance isn’t limited by age. Read More
-

How to Read Your Prescription Label
Confused by your medication label? Discover how to read your prescription label and avoid common mistakes for safe, effective treatment. Read More
-

Stroke Prevention Strategies: Secrets from the Latest Science
Here’s what we’ll cover in this blog post: A stroke isn’t just a sudden event, but the culmination of decades of cellular damage that silently builds in the body. It’s … Continue reading “Stroke Prevention Strategies: Secrets from the Latest Science” Read More
-

Beyond Diabetes: How Metformin Lowers Copper, Iron, and Zinc
A new BMJ study shows Metformin may alter copper, iron, and zinc levels. Here’s what the research means and why it matters for longevity. Read More



